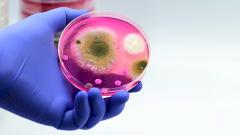
Ученые обнаружили новую грибковую инфекцию, которая еще не встречалась у людей

Как лечат больных коронавирусом в автомобильных торговых центрах?

Светлана Горелик на своей странице в социальной сети Facebook опубликовала историю своей госпитализации в АТЦ. Мы публикуем текст без изменений с разрешения автора.

Тяжелая получилась эта последняя на сегодняшний день волна. Болеет значительная часть знакомых, коллег и заказчиков, многим предлагают госпитализацию — в Москве с этим нет проблем.
Странно мне, но есть те, кто от госпитализации отказывается, но, откровенно говоря, когда доктор сказал, что едем в автомобильный торговый центр «Москва», меня накрыл страх.
— Там хоть лекарства-то есть? — спросила я доктора
— Современный крупный госпиталь. Нет причин волноваться, — бодро ответил доктор
— Знаете, доктор, — начала я, казалось бы, издалека.
— Знаю, — резко оборвал доктор, — каждый день этот госпиталь вижу.
В приемном отделении все было на удивление быстро: зарегистрировали, забрали верхнюю одежду, разрешили пройти в отделение в бахилах поверх обуви, так как я забыла тапки. Отправили в бокс на анализы.
Давление нереально низкое, ледяные руки и ноги — кровь не идет. Поили с ложки горячим чаем с сахаром — стакан держать не могла, растирали руки — смогли взять кровь в достаточном для анализа количестве. Врач и медбрат искренне радовались, что удачно, и кровь не свернулась, и не придется колоть меня еще раз.
Выдали косметичку со средствами гигиены: мыло, шампунь, зубная щетка и паста, расческа, палочки для ушей и ватные диски, маска для сна, беруши, крем для рук, шоколадка. В отделении выдали полотенце для лица и рук.
Проводили в отделение, принесли обед, который по графику был два часа назад, положили под кислород.
Через два часа принесли результаты анализов — поставили первую капельницу.
- Каждый этаж АТЦ «Москва» разделен на блоки, в которых лежат однотипные пациенты одного пола и возрастного диапазона.
- Кровати мобильные, хирургические с регулируемой верхней частью. Розетка, кнопка вызова персонала, кислородная маска и индивидуальное освещение. Есть небольшая тумбочка, сумки под кроватью.
- Каждые 10 метров стоит кулер, одноразовые стаканы для чая, чай в пакетиках черный, зеленый и шиповник, сахар в порционных упаковках.
- После завтрака там же складывают оставшиеся булочки, печенье, сладости.
- Там же упаковки с водой, разлитой в 300-граммовые бутылочки. Качество воды превосходное — это я утверждаю как потребитель воды из-под мощного фильтра.
- Персонал в защитных костюмах, у каждого на груди и спине фломастером написана специальность и имя, например врач Марина Алексеевна, медбрат Максим, врач-физиотерапевт Алина.
- Свет в отделении достаточно яркий, но не давит, выключается на период тихого часа и после 19 часов. В остальное время зависит от смены, часто оставляют только фоновую подсветку.
- Анализы берут каждое утро, если доктору не понравились какие-то показатели, то и несколько раз в день. Лечение корректируют оперативно. В конце второго дня пришли сразу три доктора, объявили, что цитокиновый шторм и в связи с этим усиливают терапию, и дали подписать дополнительное соглашение.
- Затем каждые 12 часов капельницы с «Ильсирой», кто в теме, знает, что цена на этот препарат — от 60 000 до 70 000 руб. за разовую дозу.
Что потрясло: организованность, четкое следование протоколам, высокая квалификация персонала, внимательное и бережное отношение к пациентам.
Что шокировало: нежелание пациентов слушать и слышать докторов, потребность проверять лечебные назначения у участкового врача, знакомого педиатра, проктолога, невролога, астролога, шамана, потомственной ведьмы. Адовое упорство, уверенность в своем железобетонном здоровье даже после назначения у кровати индивидуального поста и перспективы съехать в реанимацию.
Ковидный госпиталь «Москва» совсем не похож на типовую российскую больницу, похож скорее на американский врачебный сериал, в котором мне было совсем нестрашно принимать участие.
Не болейте, друзья, но если уже болеете — не стесняйтесь вызывать скорую и не тяните с госпитализацией.